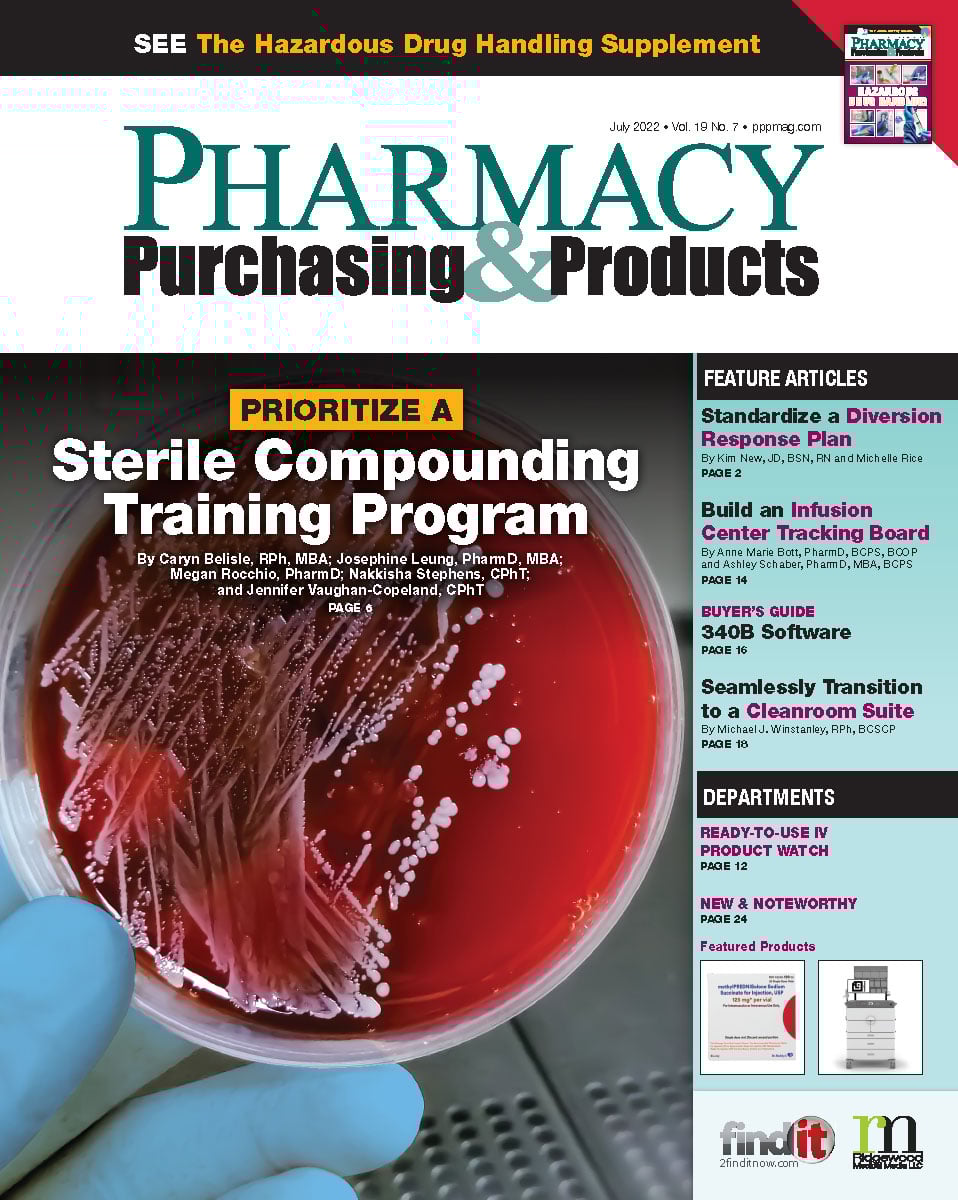
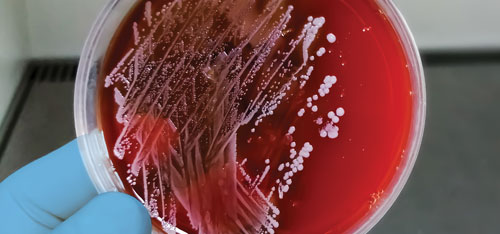

- Show Menu
- Contact Us
- FAQs
- Reader Service
- Survey Data
- Survey Winners
- Testimonials
- Upcoming Events
- Webinars
- White Papers
Recent Popular Articles
About Us
Pharmacy Purchasing & Products Ridgewood Medical Media, LLC
Quick Links
Subscribe to Our Email Newsletter!
© 2005 - 2026 PP&P Magazine - Pharmacy Purchasing & Products.
All rights reserved.